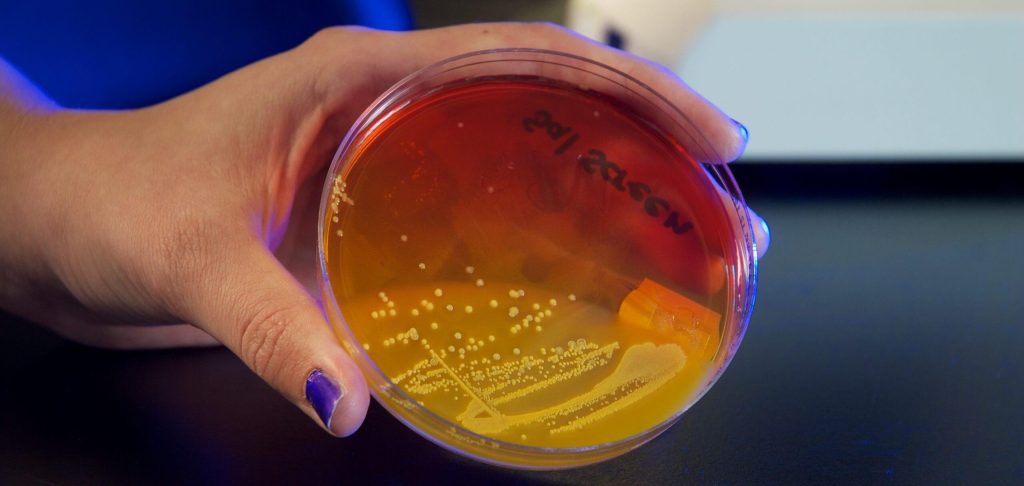

What is Sterilization Validation Testing for Reusable Devices?
The Sterilization Validation test for reusable devices confirms the appropriate Sterility Assurance Level (SAL), dry time, and thermoprofiling of the medical device. The testing establishes the pertinent sterilization parameters for health care processing instructions. Based on the data obtained through testing, the manufacturer will be able to provide health care facilities with validated sterilization parameters. Nelson Labs can validate the following modalities for sterilization; moist heat (gravity or prevacuum), ethylene oxide (EO), and dry heat. Our test validates individual devices, implants, trays, kits, reusable devices, or other devices processed at a health care facility.
Nelson Labs has the equipment and qualified personnel to help guide you through the sterilization validation test process. Our experts will provide individualized consultation and are here to help simplify the complex regulatory and standard recommendations.
We also offer cleaning validations which test the recommended cleaning procedure for a reusable device according to AAMI TIR12, AAMI TIR30, ISO 17664, and the FDA guidance document “Reprocessing Medical Devices in Health Care Settings: Validation Methods and Labeling.” This validation is necessary to assure that once the device has been used, it can be properly cleaned.
Applicable Standards
- AAMI TIR12
- AAMI ST79
- AAMI ST77
- ISO 17665
- ISO 17664
- ISO 11135